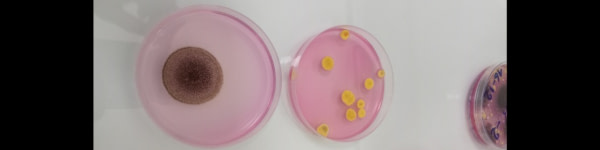
banner picture

Koffi Ali Ouattara
Technicien laboratoire/Chimiste-qualiticien

Abidjan
Tarif indicatif
N/A
Expérience
2 à 5 ans
Taux de réponse
0 %
Temps de réponse
N/A
0 posts 1 followers
Secteur d'activité
Agroalimentaire > Agrochimie
Infos
Titulaire d'un bac+2 en industrie alimentaire et chimique option contrôle qualité, je suis un produit qualifié en chimie et en contrôle qualité.
Chimiste-qualiticien de formation et technicien de laboratoire expérimenté, j'ai évolué dans un environnement sanitaire et industriel où j'ai réalisé des analyses médicales et physicochimiques, réalisé le contrôle des matières premières et produits finis, et assuré le suivi nécessaire à la qualité des procédés.
Chimiste-qualiticien de formation et technicien de laboratoire expérimenté, j'ai évolué dans un environnement sanitaire et industriel où j'ai réalisé des analyses médicales et physicochimiques, réalisé le contrôle des matières premières et produits finis, et assuré le suivi nécessaire à la qualité des procédés.
CV
Partager le profil
Vérifications
Email vérifié
Charte Go Africa signée



.jpg)


